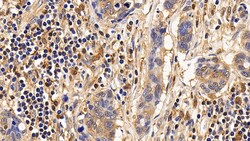
Invitrogen IL13RA2 Polyclonal Antibody, Invitrogen 20 &mu;L; Unconjugated:Antibodies,
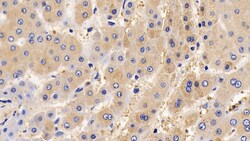
Invitrogen IL13RA2 Polyclonal Antibody, Invitrogen 20 &mu;L; Unconjugated:Antibodies,

missing translation for 'onlineSavingsMsg'
Learn More
Learn More
Invitrogen™ IL13RA2 Polyclonal Antibody, Invitrogen™
Rabbit Polyclonal Antibody
Brand: Invitrogen™ PA5145358
This item is not returnable.
View return policy
Description
IL13RA2 (interleukin-13 receptor subunit alpha-2) is closely related to IL13RA1, a subuint of the interleukin 13 receptor complex. This protein binds as a monomer to IL13 with high affinity, but lacks cytoplasmic domain, and does not appear to function as a signal mediator.
Specifications
| IL13RA2 | |
| Polyclonal | |
| Unconjugated | |
| IL13RA2 | |
| cancer/testis antigen 19; CD213a2; CT19; IL-13 receptor subunit alpha-2; IL13BP; IL13R; IL-13R; IL-13R subunit alpha-2; IL13RA2; IL-13RA2; IL-13R-alpha-2; interleukin 13 binding protein; interleukin 13 receptor alpha 2; interleukin 13 receptor alpha 2 chain; interleukin 13 receptor alpha chain 2; interleukin 13 receptor subunit alpha 2; interleukin 13 receptor, alpha 2; interleukin-13 receptor subunit alpha-2; interleukin-13 receptor subunit alpha-2-like; interleukin-13-binding protein | |
| Rabbit | |
| Antigen affinity chromatography, Protein A | |
| RUO | |
| 3598 | |
| Store at 4°C short term. For long term storage, store at -20°C, avoiding freeze/thaw cycles. | |
| Liquid |
| Immunohistochemistry (Paraffin), Western Blot, Western Blot | |
| 0.5 mg/mL | |
| PBS with 50% glycerol and 0.05% Proclin 300; pH 7.4 | |
| Q14627 | |
| IL13RA2 | |
| Recombinant Human IL13Ra2 protein, Pro238-Glu334 (Accession #Q14627). | |
| 20 μL | |
| Primary | |
| Human | |
| Antibody | |
| IgG |
Product Content Correction
Your input is important to us. Please complete this form to provide feedback related to the content on this product.
Product Title
Spot an opportunity for improvement?Share a Content Correction